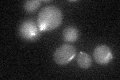
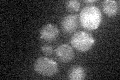

View description
Kinesin-related motor protein involved in mitotic spindle positioning, stabilizes microtubules by targeting Bik1p to the plus end; Kip2p levels are controlled during the cell cycle
Localization:
Intensity:
Fold change:
Significance:
-
C’ GFP library in SD
punctate23.11 -
N' NOP1pr-GFP in SD

punctate48.4267 -
N' TEF2pr-mCherry in SD

punctate26.0066 -
N' NATIVEpr-GFP in SD

punctate22.9939 -
N' TEF2pr-VC and Cyto-VN in SD

below threshold26.6441 -
C’ GFP library in SD+DTT

punctate24.911.07No -
C’ GFP library in SD+H2O2

punctate25.271.09No -
C’ GFP library in Starvation Media
punctate17.770.76Yes -
C’ GFP library on the background of Pup2-DaMP

punctate -
C’ GFP library on the background of CCT mutant

punctate23.82131.03074No
